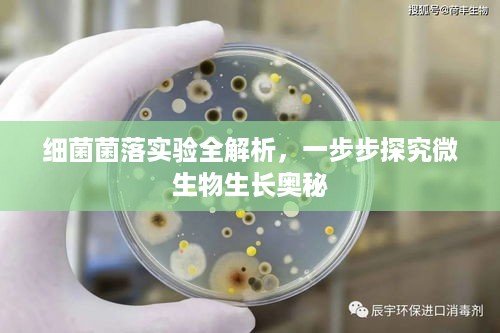

桂林与新疆,跨界旅游攻略大揭秘!
桂林与新疆,两个地方,两种风情,桂林的秀美山水与新疆的辽阔草原,共同构成了中国旅游版图中不可或缺的一部分,让我们一起走进这两个美丽的地方,探索它们的魅力,为您带来一次独特的旅行体验。桂林旅游攻略桂林,以其秀美的山水景...
励志语录助你摆脱烦恼,拥抱快乐生活
人生在世,谁都会遇到烦恼,面对生活中的种种困扰与挑战,我们需要坚定的信念和励志的力量来驱散心中的阴霾,以下是一些去烦恼励志语录,希望能为大家带来正能量,激发前行的动力。面对烦恼,心态决定一切1、烦恼如烟,只需一缕清风...
网络电话频繁打扰,新型沟通方式还是骚扰行为?
随着科技的飞速发展,网络电话作为一种便捷的通讯方式,已经逐渐渗透到人们的日常生活中,当“网络不断打电话”这一现象频繁发生时,它带来的影响也逐渐引起了人们的关注,这种现象背后究竟隐藏着怎样的原因?它究竟是一种新型骚扰,...
河源甜品小吃TOP10榜单揭晓,味蕾盛宴的美味之旅
河源,这座美丽的城市不仅拥有迷人的自然风光,其美食文化也独具魅力,甜品小吃作为当地美食文化的重要组成部分,以其丰富多样的口味和独特的风味赢得了广大食客的喜爱,让我们一同探寻河源甜品小吃排名前十名,感受这些美味佳肴的魅...
江苏船员突发疾病紧急救援行动,关爱与生命同行视频记录
一段关于江苏某海域船员突发疾病的视频在网络上广泛传播,引发了社会各界的关注和关心,该视频记录了一场紧急救援行动,同时也凸显了对于船员这一特殊职业的关注和关爱的重要性。视频中,江苏某海域的一艘船只上,一名船员突然感到身...
如何安慰面对突发疾病的亲友,贴心建议助你传递温暖关怀
生活中的突发疾病无疑是一场突如其来的风暴,给人们的身心健康带来困扰和不安,面对这样的情况,除了提供实质性的帮助外,我们还需要用温暖的话语给予安慰,帮助他们度过难关,对于突发疾病怎么安慰呢?接纳并认同他们的感受要明白突...
扎实落实构建成功基石,打造坚实根基,助力事业腾飞
在当今社会,无论是企业、组织还是个人,要想取得成功,必须注重落实各项工作的扎实性,只有真正将每一项任务、每一个计划、每一个决策落到实处,才能取得预期的成果,本文将探讨如何扎实地落实各项工作,并阐述其重要性。扎实落实各...
洛阳专利代理公司权威排名榜单揭晓!
洛阳,这座历史悠久的城市,随着科技的进步和创新的发展,专利代理业务也逐渐崭露头角,越来越多的企业和个人开始重视专利的申请和保护,这也促使洛阳的专利代理公司如雨后春笋般涌现,在众多的洛阳专利代理公司中,哪些公司名列前茅...
九价疫苗深度解析,女性健康的新里程碑保护者
随着人们对健康的关注度不断提高,疫苗的重要性也日益凸显,在众多疫苗中,九价疫苗以其预防疾病范围的广泛性和适用人群的特定性,成为了公众关注的焦点,本文将为您带来一场关于九价疫苗的深度报道,带您了解这一护航女性健康的新里...
细菌菌落实验全解析,一步步探究微生物生长奥秘
实验目的通过细菌菌落实验,学习并掌握细菌培养和菌落观察的基本技术,了解细菌的生理特性及环境条件对其生长的影响。实验原理细菌菌落实验是通过将细菌接种在固体培养基上,观察其生长过程及菌落特征,从而了解细菌的生长规律、形态...

蜀ICP备2022005971号-1